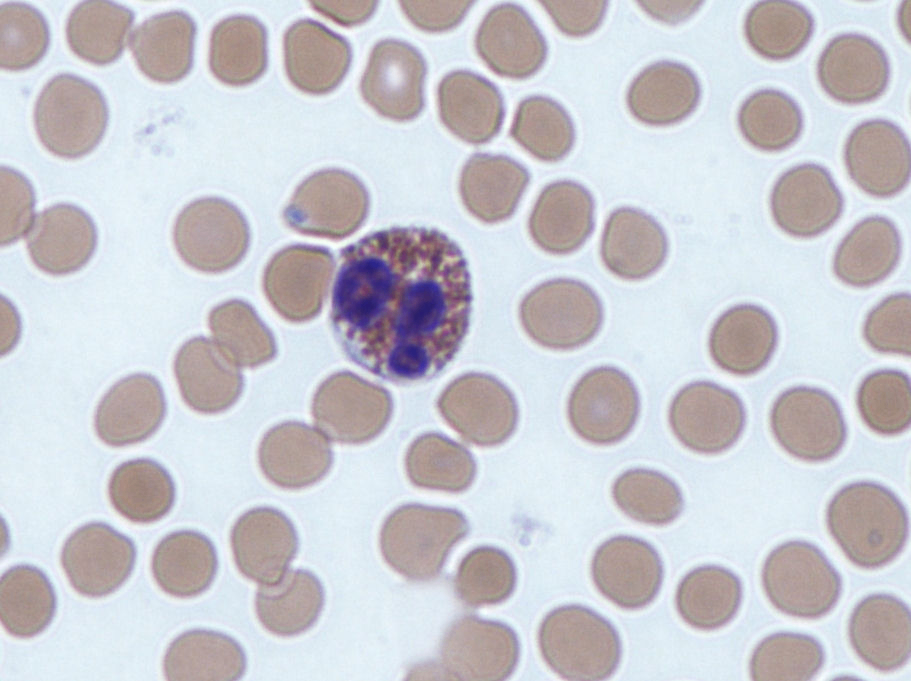

호산구 (Eosinophil)
이론과 하이라이트 히스토리를 확인 할 수 있어요.
1. 개요
1) 백혈구의 한 종류로, 기생충 감염, 알레르기 반응, 그리고 염증 조절에 중요한 역할을 하는 과립세포(granulocyte).
2) 혈액 내 백혈구 중 약 1~4%를 차지한다.
2. 형태
항목 | 특징 |
|---|---|
핵 | 2개 엽(bilobed nucleus) |
과립 | 크고 선명한 호산성 과립 (eosin으로 붉게 염색) |
세포 크기 | 대략 12–17μm |
3. 역할
이론부터 문제까지, 알렌의 서재를 100% 활용하세요
※ 로그인 후 이용권 구매 시 전체 이용 가능합니다.
6,000개 이상의 문제와 연결되는 이론으로 개념과 적용을 한 번에
실제 국시와 동일한 CBT 환경으로 실전 감각 완성
틀린 문제를 매일 자동으로 챙겨주는 ‘오늘의 문제’
메모·암기카드·노트로 만드는 나만의 복습노트
제한 없이 학습 시작하기
이용권을 구매했다면 로그인 하기
커뮤니티 Q&A
위 이론과 관련된 게시글이에요.
이해가 안 되거나 궁금한 점이 있다면 커뮤니티에 질문해 보세요!
로그인